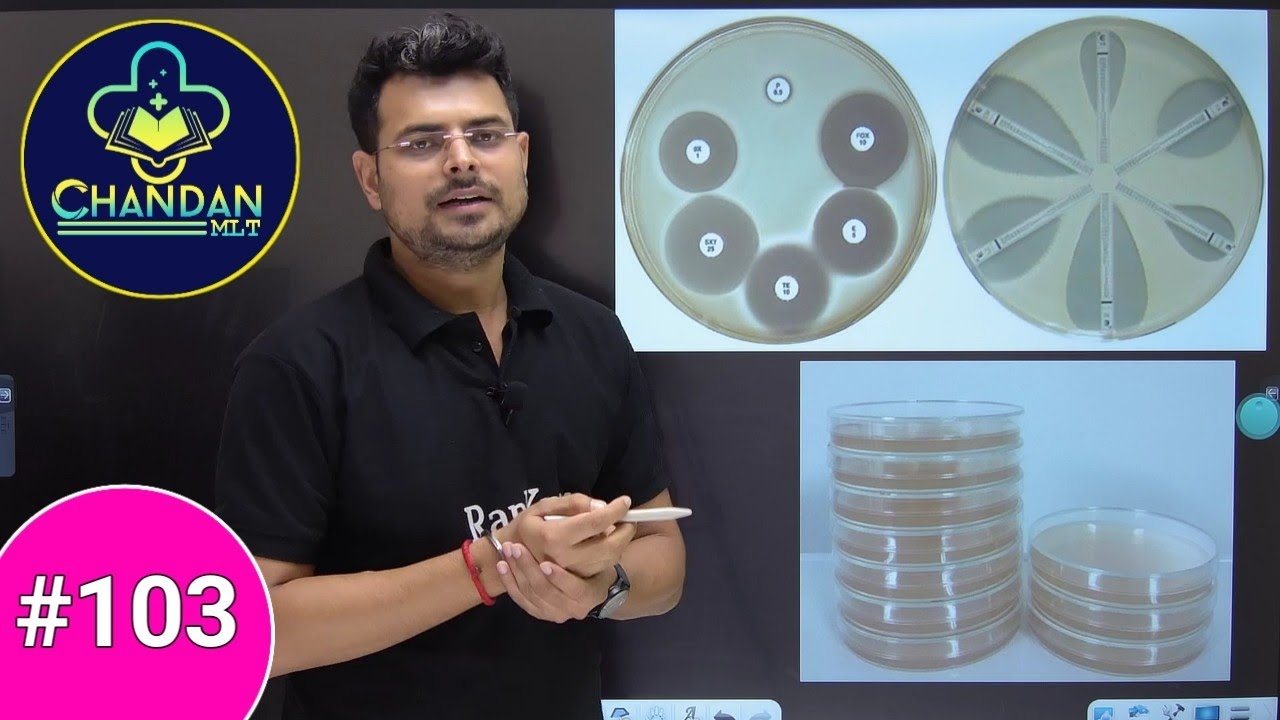
LAB TECHNICIAN MCQ'S #103 | lab technician classes | Chandan Mlt

Lab technician MCQs series #58
Автор: Chandan Mlt (RanKplus - the Learning App)
Загружено: 2020-10-24
Просмотров: 27050
Описание:
Lab technician MCQs series #58
We also conduct classes of lab technician competitive exam preparation | Chandan Mlt | Group 5 | RPMC | DRDO, PGIMER, AIIMS, DHA, DSSSB, RAILWAY, SGPGI, ESIC, Safdarjung hospital classes.
These all classes will help you in the Lab technician exams, Lab technologist exam, lab assistant exam, lab superintendent exam, sgpgi exam, pgi Chandigarh (PGIMER) , AIIMS exam, RPMSC exam, etc. For better preparation you can join the classes on RanKplus App or on our Official Website : https://rankplusofficial.com/ explain by Chandan Mlt (RanKplus - the Learning App).
India's Best paramedical classes provided By Chandan mlt sir.....
We provide All paramedical solution like Live classes, Video Lectures, pdf Notes, Online Test series, Mcqs video for Lab technician exam, MCQ's pdf etc......
Join us to improve Your skill and preparation environment for All formats of Lab Exams, Lab Technician Exam, Group -5 Lab technician exam, Lab superintendent exam, Lab assistant exam, Lab DHA prometric exam etc.
We have most demanded and searchable Faculty Chandan Mlt sir for teach All these classes.
IMPORTANT LINKS :-
✅ Download RanKplus - the Learning App:- https://play.google.com/store/apps/de...
✅RanKplus Official Website :- https://rankplusofficial.com/
✅ RanKplus Twitter:- https://twitter.com/RanKplus?t=1xYcG-...
✅ RanKplus Email : - [email protected]
☑️ RanKplus What's App :- +91 8235067766
✅ RanKplus Instagram :- https://instagram.com/rankplusofficia...
✅ RanKplus Telegram :- https://t.me/rankplusofficial
#chandanmlt #rankplus #group5mcqs #group5exam2025 #labtechniciancourse #labtechniciansyllabus #paramedical
Повторяем попытку...

Доступные форматы для скачивания:
Скачать видео
-
Информация по загрузке:
















![Пожалуй, главное заблуждение об электричестве [Veritasium]](https://imager.clipsaver.ru/6Hv2GLtnf2c/max.jpg)